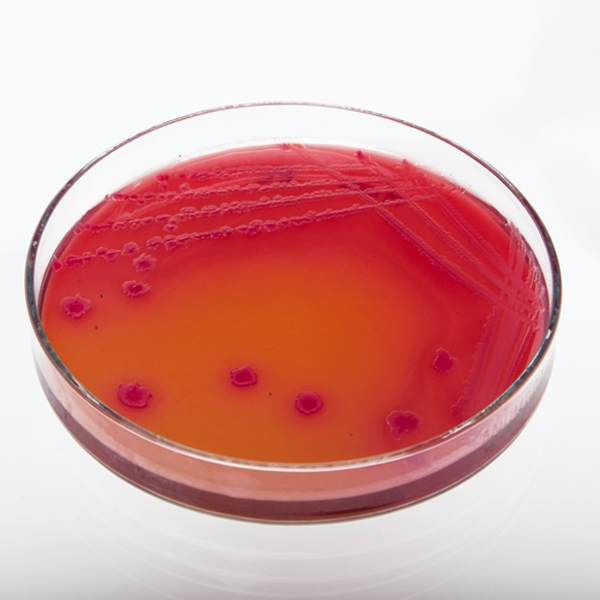
agar-web
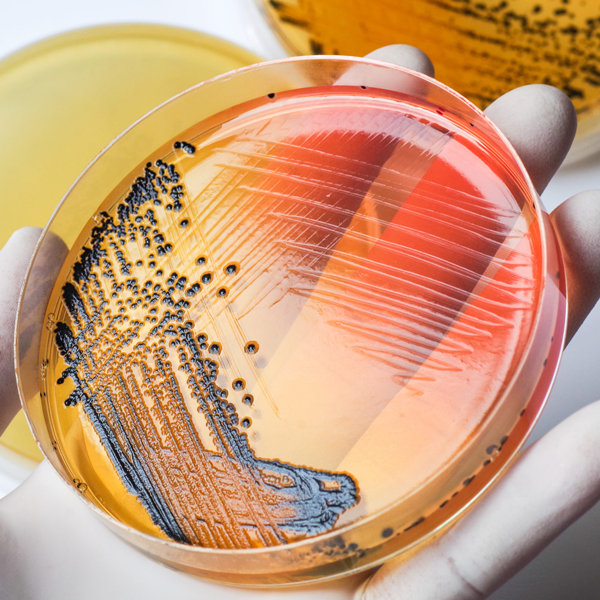
agar2-web

LOBA
CHEMIE
Empresa India con más de 40 años de experiencia en la fabricación y distribución de reactivos de laboratorio y química fina para uso Industrial que suministra más de 5.000 productos en más de 100 países en el mundo.
Sus 6 líneas de productos: Reactivos Analíticos, para Análisis de trazas, Grado Espectroscópico y Cromatográfico, Reactivos de Laboratorio Puros y Extra-puros, Reactivos para síntesis, productos para Bioquímica, Microscopía y Diagnóstico, cumplen con la pureza y requisitos de la industria farmacéutica mundial según; IP, BP, USP y EP en instalaciones aprobadas GMP y cuenta con acreditación de estándares internacionales, incluidas las certificaciones ISO, OSHAS y CE, garantizando la confianza en la calidad y consistencia de los productos, cumpliendo con las normas internacionales, asuntos regulatorios y su compromiso con la calidad.